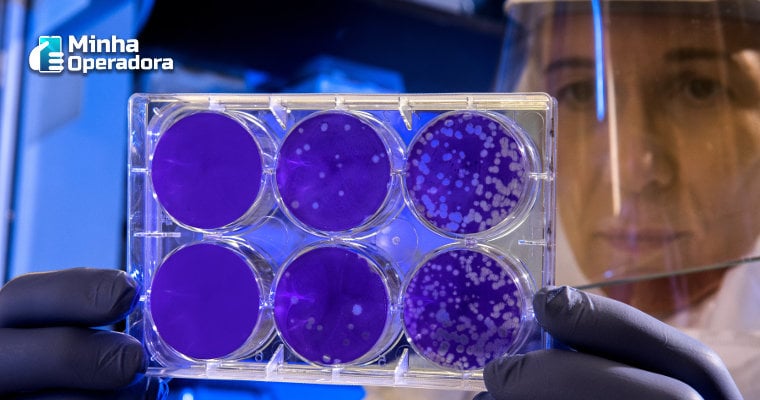

Vírus já contaminou milhares de pessoas ao redor do mundo, a maioria delas na China.
Nesta segunda-feira, 27, a ZTE, em parceria com a China Telecom, anunciou que conseguiu realizar um diagnóstico remoto do novo coronavírus utilizando uma rede 5G. O feito foi realizado na província de Sichuan, na China, demonstrando o potencial da nova rede de telefonia.
Na semana passada, a fabricante construiu e interconectou estações-base 5G internas em um centro remoto de diagnóstico e tratamento de doença. Com isso, foi possível realizar uma consulta remota por vídeo, com participantes do West China Hospital, do Centro de Clínica de Saúde Pública de Chengdu e da Comissão de Saúde de Sichuan.
O West China Hospital será o nó central do sistema 5G, e terá acesso a 27 hospitais que aceitaram tratar pacientes com o novo coronavírus de 2019.
A ZTE também está implantando uma rede 5G em um segundo hospital improvisado, em Wuhan, para auxiliar o tratamento do paciente, provavelmente através de consultas remotas. O hospital deve iniciar as operações a partir de 5 de fevereiro de 2020.
VIU ISSO?
–> Brasil foi o país que mais testou 5G em 2019
–> Leilão do 5G é apresentado para investidores
–> Com 5G atrasado, Brasil já estuda protocolo do 6G
Um coronavírus é um tipo de vírus comum que causa uma infecção no nariz, seios nasais ou garganta superior. A maioria dos coronavírus não é perigosa, no entanto, no início de janeiro, a Organização Mundial da Saúde (OMS) identificou um novo tipo, o novo coronavírus de 2019 (2019-nCoV) na China, que tem um risco de contaminação internacional classificado como elevado.
Até agora, mais de 2,7 mil casos foram confirmados e 81 mortes registradas. Ainda não há tratamento eficazes para a doença.
Com informações de Gizmochina e G1.












